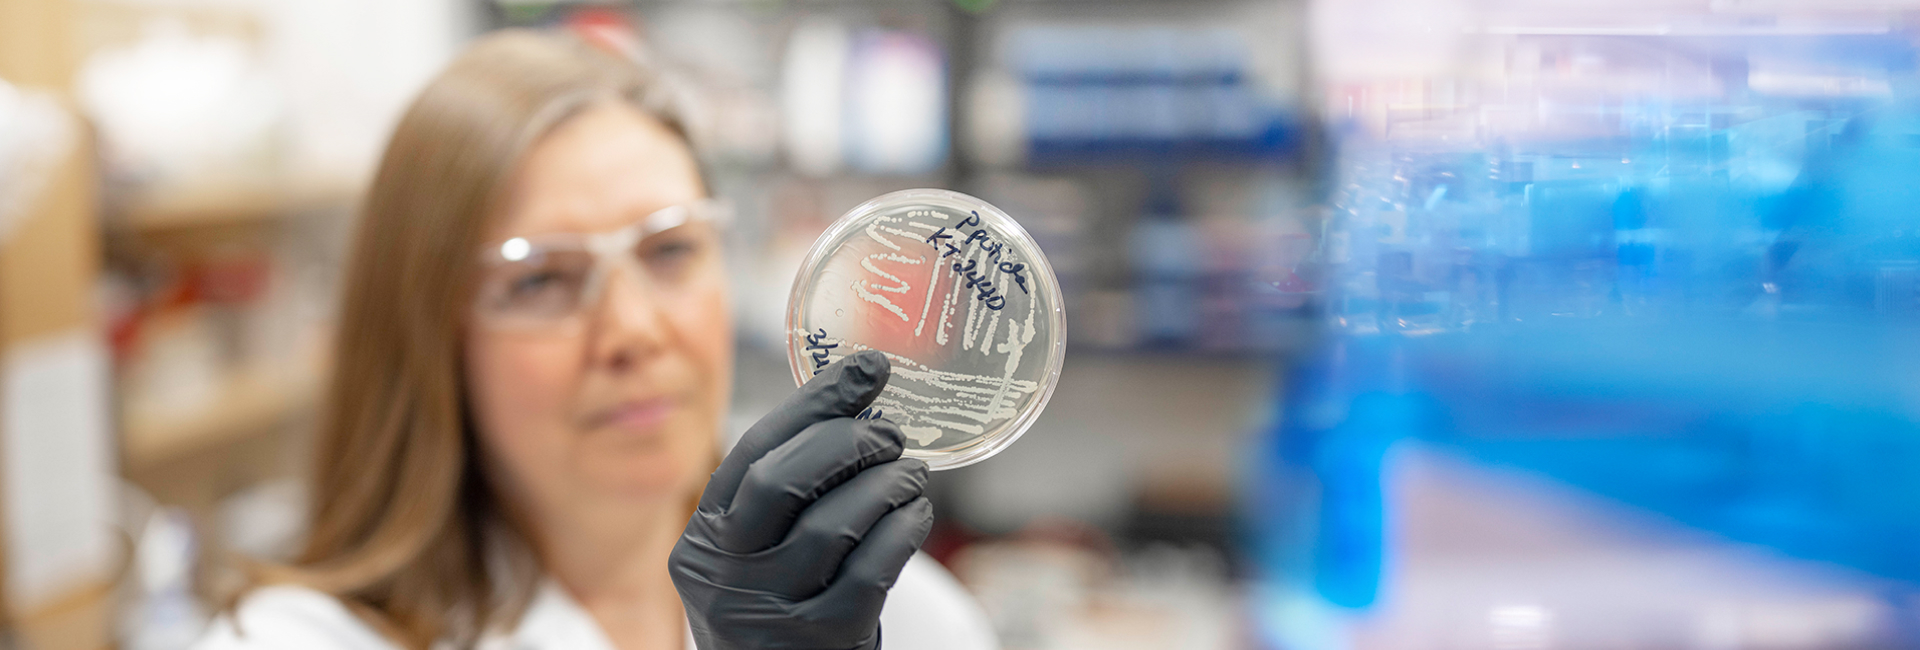

Tanja Dominko, DVM, PhD, associate professor of biology and biotechnology at Worcester Polytechnic Institute (WPI), is the 2013 Slovenian Ambassador of Science, a national award given to one Slovenian native each year in recognition of outstanding achievements and global scientific impact. The award also honors Dominko’s international engagement in developing programs that bring together WPI students and faculty members with Slovenian colleagues to address important biomedical challenges.
Slovenian President Borut Pahor presided at the awards ceremony on Nov. 22, 2013, in the city of Maribor, where Dominko joined nine other scientists and engineers who received national awards for a range of accomplishments. At the event, President Pahor spoke of the vital need to support scientific research and education on a global basis to help improve the human condition—a message that Dominko says resonates deeply with her personal and professional goals to discover and translate new knowledge of human physiology to help cure disease.
"When I learned that I was selected, it was a special moment," she said. "Knowing that after working in the United States for 23 years, that the people of my homeland recognized the value of what we have been doing here gave me a sweet feeling inside. What is most important, though, is the work we are continuing to do, both here at WPI and at the University of Nova Gorica in Slovenia, to help make regenerative cell therapies a reality for all people, regardless of where they live or their ability to pay for treatment."
In a written statement congratulating Dominko for her award, Dr. Božo Cerar, Slovenian Ambassador to the United States, said, "I wish to express my sincere compliments for your outstanding work in the area of stem cell research, regenerative medicine, and tissue engineering, moreover for your valuable role in promoting education and awareness about the fields, both in Slovenia and in the United States."
Dominko is globally recognized for her research in stem cell biology and regenerative medicine. Her work has spanned embryonic transfer, cloning through somatic cell nuclear transfer, and the basic science of early embryogenesis. She is currently at the forefront of the science of cellular reprograming, exploring how mature human skin cells can be coaxed to become more like stem cells able to recapitulate damaged tissues throughout the body.
"This is wonderful recognition for an important body of work and for Tanja’s ongoing commitment to advance science and education," said Karen Kashmanian Oates, Peterson Family Dean of Arts and Sciences at WPI. "Through her efforts, Tanja not only honors her homeland, but brings honor to WPI and the faculty and students who work with her. Tanja’s engagement of science across borders has created informal, yet essential, networks of science diplomacy. We look forward to the exciting work that will come from these collaborations."
After earning an MS in large animal reproduction and obstetrics and a doctor of veterinary medicine degree from the University of Ljubljana in Slovenia, Dominko came to the United States in 1990 to enroll in a graduate program at the University of Wisconsin-Madison. There she earned a PhD in endocrinology and reproductive physiology, working in the lab next door to Professor Jamie Thomson, who made history by isolating the first embryonic stem cells, initially from primates and then from humans.
"I have always been interested in reproductive physiology, and when I was at Madison two important things happened that shaped my career," Dominko says. "First, there were the discoveries by Jamie Thomson. Then, two of my friends, Ian Wilmut and the late Keith Campbell in the UK, successfully cloned the sheep Dolly. So I guess it was a case of being in the right place at the right time, to be connected with these people, and then to be able to move my work into the area of stem cell biology, cloning, and ultimately regenerative cellular therapies."
After a postdoctoral fellowship at Madison, and another in the lab of Gerald Schatten, PhD, at the Oregon Health Sciences University in Portland, Dominko was recruited to Worcester for a senior research position at Advanced Cell Technology Inc. She came to WPI in 2006 as an assistant research professor and CEO of a start-up company she founded called CellThera, which moved into WPI’s Bioengineering Institute. In 2008 Dominko was appointed associate professor of biology and biotechnology at WPI; she received tenure in 2012.
In recent years, Dominko has become increasingly active with colleagues in Slovenia. She has organized a series of biotechnology courses and seminars in Slovenia for scientists and graduate students. Several WPI life sciences professors have lectured in Slovenia at Dominko’s invitation. Her work in Slovenia accelerated in 2011 when she was invited by Dr. Danilo Zavrtanik, president of the University of Nova Gorica, to develop a new center to focus on the science of aging and the development of biomedical technologies to help an aging population. The result was the Center for Biomedical Sciences and Engineering at UNG, where Dominko is the founding director.
The center now has seven full-time faculty members and a growing research portfolio. This year 15 WPI undergraduates are working on their Major Qualifying Projects (MQPs) in Slovenia. "Things are coming together beautifully at the center," Dominko said. "It’s been a wonderful experience, not just for me, but for all the scientists and students involved. Today, science is a global effort. The more we bring bright people together across borders and cultures to work collaboratively, the more success we will see. And that will translate into making a positive impact on human health. That’s what it’s all about."